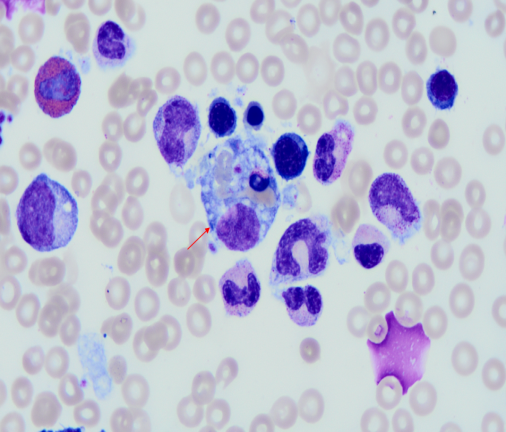

保山二院医学检验科,既有显微镜下探寻真相的执着,也有AI算法破解疑难的热忱;既有为抢救危重患者争分夺秒的惊心动魄,也有为病患儿童轻拭泪水的温柔瞬间。作为隆阳区区域医疗中心的中坚力量,我们以“技术有深度、服务有温度、创新有准度”为理念,用适配市级医院的实用型新技术与人文关怀,架起连接精准医学与百姓需求的桥梁。
技术突围:
让检验中心成为区域诊断“中流砥柱”
案例1:
2024年7月,一名患儿出现无明显诱因发热,发热忽热忽凉,最高体温40.0℃,发热时伴有寒战,无抽搐及意识障碍,辗转多家医院未确诊。患儿入我院后,查体左肩可见一约0.5cm大小焦痂样皮疹,完善血常规、凝血、生化免疫等检查,回示肝功能损害、肾功、心肌酶异常,凝血功能异常,血常规三系均减低,存在多器官功能损伤情况,临床诊断考虑恙虫病,结合患儿三系减低,还需警惕儿童白血病,鉴别诊断嗜血细胞综合征,予完善外周血细胞形态学观察及骨穿检查。最终通过“骨髓细胞形态学检查”,标本送检次日上午,仅两个多小时,我科检验医师龚倩在外周血涂片中发现患儿存在严重感染,在骨髓涂片中发现“嗜血细胞”,在签发诊断报告后与临床及时沟通,后邀请昆明市儿童医院血液科黄体龙主任远程会诊:“患儿可诊断噬血细胞综合征(HLH),考虑恙虫病继发HLH。”
至此,患儿诊断明确,治疗上继续给与“多西环素+美罗培南”抗感染,“甲泼尼龙琥珀酸钠”抗炎,“异丙托溴铵+布地奈德”雾化治疗,后病情好转出院。
小链接
噬血细胞综合征(hemophagocytic syndrome,HPS),又称为噬血细胞性淋巴组织细胞增多症(hemophagocytic lymphohistiocytosis,HLH),是一种遗传性或获得性免疫调节功能异常导致的严重炎症反应综合征。HLH 缺乏特异性临床表现,因此容易误诊、漏诊;由于 HLH 的潜在病因多种多样,首诊科室较多,存在多学科交叉的特点。HLH 是一种进展迅速的高致死性疾病,HLH 未经治疗的中位生存时间不超过 2个月。感染是继发性HLH的常见原因,占总病例的70%;第二大常见病因是肿瘤相关性HLH(血液学和非血液学),16%的病例是由恶性肿瘤(血液和非血液系统)引起的;风湿免疫病相关HLH占第三位,感染诱因和药物等可能是HLH重要的触发因素。值得注意的是,如在临床期间未能判定嗜血细胞活动,进一步寻找嗜血细胞活动则十分必要,如从骨髓标本中不能得到阳性结果,还可检查其他器官,连续的骨髓穿刺有助于诊断。
案例2:
自动化升级:2020年建成标准化分子实验室,现开展HPV分型、呼吸道病原体联检、HCV-RNA检查等34项检测,年检测量突破15000例。2024年7月,我院北院区中心实验室正式开诊,引入多台高精尖设备,包括全自动生化免疫流水线、全自动血细胞分析流水线+推染仪+阅片仪、全自动尿液分析流水线、阴道微生态检测系统、全自动粪便分析仪、微生物质谱等,单日处理能力达10000人次,急诊报告缩短至1小时。
人文创新:当技术遇见温情
暖心场景:“医生,一次性采3、4管血会不会影响健康?”、“医生,可以采一管血做多项检查吗”,面对老人李大爷的担忧,医学检验科“急病人所急,想病人所想”,主动整合检测项目,避免同一时间段内多次采血,减少总体采血量。此外,应用高效检测设备,能够在同一份标本上完成多项检测。科室人员对患者认真沟通、耐心解答,让老人连连感慨:“现在看病省心多了!”
未来蓝图
1.打造特色区域检验中心:扩建微生物、质谱、测序、流式检测平台,承担周边县区耐药菌基因检测,药物浓度测定、自身免疫性疾病相关检测等。
2.智慧实验室2.0:引入AI血细胞形态学筛查系统,疑难血液病诊断准确率提升≥95%。
3.健康惠民项目:通过科研立项,启动“肿瘤早筛行动”,为肿瘤高危人群提供免费检测。
在保山市第二人民医院医学检验科,我们深知:检验中心的技术创新,不是盲目追逐“高精尖”,而是让先进技术“接地气”、让精准诊断“可触及”。从一份报告的精准解读,到一项技术的普惠推广,我们始终以“创新、担当”精神,守护一方百姓健康。
本院专家

杨 洪
中共党员,医学检验科主任兼第六党支部副书记,副主任技师
保山市医学会检验医学分会副主任委员
保山市临床检验质量控制中心委员
保山市“十四五”重点专科负责人
从事医学检验工作23年,期间担任党办主任2年,多次被评为区、院级优秀党务工作者,2015年至上海市公共卫生中心进修实验室管理,年均审核报告2万余人次。
近年来,参与云南省科技厅重大专项1项,云南省检验医学重点实验室开放课题1项,参与保山市科技技术局医学联合专项面上项目2项、青年项目2项,北京市医学基金课题1项,发表专业论文5篇。


龚 倩
中共党员,医学检验科副主任,执业医师、主管检验技师
全国本科毕业论文(设计)抽检评审专家库专家
保山市医学会血液学分会委员
主持、参与保山市科技技术局医学联合专项市级课题2项,发表论文及科普文章2篇。曾到至云南省第一人民医院进修骨髓细胞学;浙江大学医学院附属邵逸夫医院进修质谱及流式细胞学,擅长实验室管理、临床血液、体液细胞形态,流式细胞学、高效液相色谱串联质谱技术。


杨洪珠
医学检验科副主任,主管检验技师
在SCI发表论文1篇,在普刊发表论文1篇,主持市级课题1项
擅长生化、免疫学,实验室质量管理等工作曾到云南省第一人民医院进修血液、体液学;昆明医科大学第二附属医院进修输血学,上海交通大学医学院附属瑞金医院进修临床生化、免疫学。


供稿|医学检验科
扫一扫在手机打开当前页